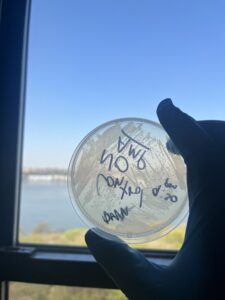

Weeks 1 to 4: Lab time!
April 25, 2025
Alright, we’re back! This week, I went all in—mixing my own LB broth, streaking plates on my dining table, sterilizing old jars in a pot like some weird science-soup hybrid, and trying to convince my bacteria to actually do something.
I measured out some Luria Broth (Miller’s) powder — not with a lab balance, but with a pocket scale that probably sees more use weighing coffee beans than microbiology supplies. I mixed the powder into distilled water and heated it in 30-second microwave bursts. The goal was to get it hot enough to sterilize without exploding all over the inside of the microwave. It was one of those moments where you realize how little control you actually have over microwaves, but somehow it worked. You can see the setup in one of the photos — a bowl, some plastic wrap, and a plate are involved. It was chaos. But it worked.
With the broth ready, I needed something sterile to store it in. I found a glass jar that used to hold bone broth, boiled it in a pot on the stove for about 15 minutes, and then cooled it in an ice bath before pouring in the hot LB. The whole thing felt very Frankenstein meets DIY cooking show. But honestly? That jar turned out to be one of the most reliable parts of this entire experiment.
I filled two 15 mL conical tubes with the cooled LB, added a few drops of liquid E. coli from a Carolina culture tube, loosely capped them, and put them in my 37°C incubator. I also streaked some of the culture onto an agar plate I had poured earlier with my freshly made LB agar. The plates came out surprisingly clean, considering I poured them on my kitchen table with the precision of someone pouring pancake batter while half-asleep. Still, they solidified nicely and looked good enough to use.
Thirteen hours later, I checked in. The tubes looked… the same. Maybe one of them was slightly hazy, but it was one of those “is this actually cloudy or am I just convincing myself it is?” kind of situations. But when I checked the streaked plate, there was definitely some faint growth. Barely visible, almost like condensation lines, but it was there. You can see it in one of the photos. It made me realize: the culture was alive, just starting slowly. Probably because I had used LB straight out of the fridge like a rookie.
Since the broth didn’t seem to be doing much, I decided to give it a boost. I took a sterile loop, grabbed a bit of the faint growth from the plate, and swirled it into the same broth tubes. That wasn’t part of the original plan, but at this point, the whole project was held together with good intentions and duct tape anyway. I figured the worst-case scenario was that nothing would change, and the best case was a culture that actually grew. Sometimes you just gotta improvise.
The rest of the night was me periodically checking the tubes, giving them gentle swirls, and hoping they’d eventually hit turbidity. I didn’t have a shaker, so I gave them a manual shake every couple of hours like some weird bacterial babysitter. It kind of worked — the next day, the difference between the inoculated tube and the control was clear. It wasn’t dramatic, but it was definitely cloudy. Not a perfect overnight culture, but it was alive, and that was good enough for me!
Now, I am working on transformation. Wish me luck!

Leave a Reply
You must be logged in to post a comment.